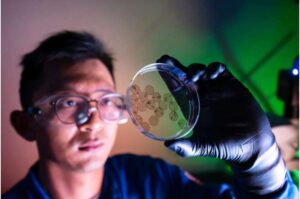

Volition Announces Detection of Over 95% of Early-Stage Cancers
Blinded validation cohort achieves over 95% sensitivity for stage I & II cancers with 95% specificity

Blinded validation cohort achieves over 95% sensitivity for stage I & II cancers with 95% specificity

A Penn Medicine–led team has developed a first-of-its-kind artificial intelligence system that interprets cardiac MRI scans with performance approaching expert clinicians.

We have never had a model that accurately mimics both the key physical and functional properties in the esophagus or gastrointestinal tract.

A new study in pet dogs treated with promising novel treatment regimens for the same cancer suggests that immune signatures found in blood samples could help identify poor responders early.
What we’ve built is essentially a light-powered interface that speaks in electrical and mechanical pulses, the same language as the heart, without any of the drawbacks of rigid electrodes